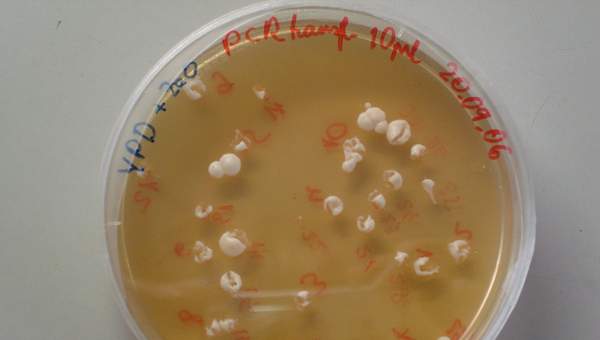
Levaduras en placa Levaduras en placa
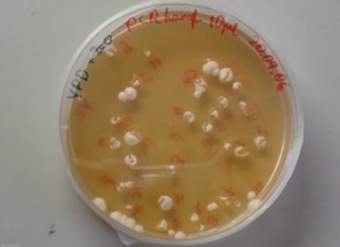
Levaduras en placa Levaduras en placa

Levaduras en placa
Imagen color
Levaduras en placa393.7kb
Levaduras en placa12.9kb
Descripción
Imagen color
Investigar e identificar algunos microorganismos beneficiosos y dañinos para la salud (bacterias, virus y hongos), y proponer medidas de cuidado e higiene del cuerpo.
Unidad 3: Efectos del cigarrillo. Agentes infecciosos. Conductas saludables.
Tipo: Imágenes y multimedia / Imágenes
Curso: 5° básico
Asignatura: Ciencias Naturales
Fuente o Colección: Currículum en línea
Autor: Commons Wikipedia
Modalidad: Educación General
Palabras claves: Microrganismos beneficiosos / Hábitos saludables / higiene / salud / microrganismos dañinos / patógenos